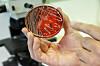
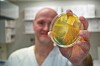

UTVALGTE STILLINGER:
-
Administrerende direktør
Søknadsfrist: 09.07.2026
-
Stipendiat - Avdeling for omsorg og etikk
Søknadsfrist: 10.08.2026
-
Researcher (SKO 1109) - ARENA (Second round of recruitment)
Deadline: 16.08.2026
-
Postdoctoral Fellow in Peace and Security in the High North
Deadline: 15.09.2026
-
Forsker innen generativ KI, desinformasjon og demokrati
Søknadsfrist: 15.08.2026
Annonse
Annonse
Annonse
Annonse
Annonse